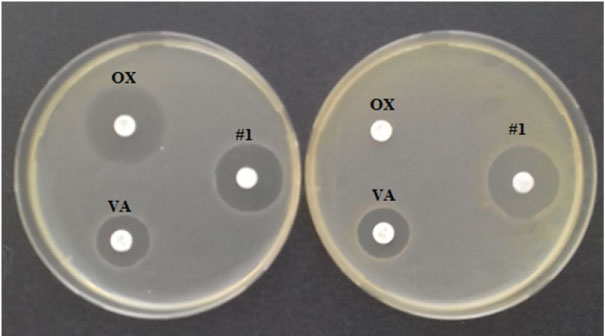

The effectiveness of antibiotic therapy is constantly decreasing due to the increasing spread of resistant pathogens. One alternative treatment for infections is the use of probiotics - living microorganisms that contribute to the normalization of the human microbiota. The aim of this study is to determine the antibiotic properties of the strain 534 as the intended basis of its probiotic activity.
The object of our research is the transient probiotic strain Bacillus subtilis 534 that is a basis of the drug Sporobacterin. The strain 534 was cultivated in submerged conditions and the obtained culture liquid (CL) was investigated for antimicrobial activity by diffusion into the agar medium method. As test objects, collection strains of bacteria and fungi were used as well as clinical isolates with different resistance to antibiotics. For preliminary chemical characterization, CL was passed through a column with Amberlite XAD-2 sorbent. Аntimicrobial components were desorbed with mix of n-butanol-acetone-water (1:1:1), resulting eluates were evaporated in vacuum to dryness and was dissolved in aqueous ethanol. The next purification of the antimicrobial components was performed in the column filled with Kieselgel 60 silica gel (Merck) using stepwise elution with chloroform-methanol solvents in different proportions. For determination of the active fractions, test strains of Staphylococcus aureus INA 00761 (methicillin-resistant S. aureus - MRSA) and Saccharomyces cerevisiae RIA 259 were used.
Under submerged cultivation, the strain 534 produces antimicrobial substances that suppress the growth of Gram-positive bacteria and fungi. The CL of the strain 534 inhibits the growth not only the test strains, but also clinical isolates with different antimicrobial resistance of the following Gram-positive bacteria and fungi: Staphylococcus aureus, S. epidermidis, S. capitis sbsp. urealyticus, Сandidaalbicans, С. glabrata, C. lusitaniae, Cryptococcus neoformans, Prototheca sp., Trichosporon sp. Although no activity against Gram-negative bacteria was detected in the CL, such activity was detected after CL concentration of approximately 800 times including activity against some clinical isolates of multidrug-resistant bacteria of the Klebsiella pneumonia and Acinetobacter baumannii species.
The spectrum of antimicrobial activity of CL indicates the ability of the probiotic strain B. subtilis 534 to produce antimicrobial substances active against wide range of bacteria and fungi, including those resistant to modern medical antibiotics. We consider this strain as a producer of antibiotics that overcome the drug resistance of pathogenic microorganisms and plan its further chemical research.
Antibiotic resistance, Pathogenic microorganisms, Antimicrobial activity, Bacillus subtilis 534, Probiotic Sporobacterin
The use of antibiotics in medicine began during the Second World War, but over the past decades, the effectiveness of antibiotic therapy is constantly decreasing due resistance development of pathogenic microorganisms [1-3]. The current situation requires the development and introduction of new antibiotics into the medical practice, as well as other antimicrobial drugs. The latter include probiotics - drugs, which are based on living microorganisms that contribute to the normalization of the human microbiota. The term "probiotic" is also applied directly to probiotic microorganisms. The action of probiotics is multifactorial in nature, and one of the active principles is the formation of antibiotic substances that help restore the balance of microbiota. A valuable property of many probiotics is the lack of toxicity [4].
Probiotic microorganisms include such inhabitants of the intestine as streptococci, lactobacilli and bifidobacteria, as well as transient microorganisms, i.e. temporarily present in the human body. In particular, hay bacillus (Bacillus subtilis), which is widely distributed in nature and enters the human body with water and food, gives grounds for some researchers to consider this bacterium as a normal intestinal microbiota inhabitant [5-7]. The first bacillary probiotic described was the B. subtilis strain isolated from the wound in 1945 [8]. The result of subsequent research was the isolation from bacilli many antibiotics of different structure, active against both Gram-positive and Gram-negative microorganisms, as well as fungi [9-13]. In medical practice of different countries, biological preparations based on bacteria of the genus Bacillus are used. In Western Europe apply probiotic Baktisubtil (the company Marion Merrell, France) and its analogue Flonivin BS (the company Galenika, Slovenia). The basis of these preparations is B. cereus IP 5832 strain from the collection of the Institute Pasteur (France). Also known is the biological preparation Cereobiogen (Xing Jian, China), the active agent of which is B. cereus strain DM-423. The Vietnamese drug Biosubtil as an active ingredient contains the strain B. subtilis. Three bacilli-based drugs have been registered in Russia: Biosporin, Sporobacterin, Baktisporin. Biosporin is the only complex drug, which is based on two strains - B. subtilis 2335 and B. licheniformis 2336. Sporobacterin and Bactisporin are based on B. subtilis strains - 534 and 3H respectively.
The drug Sporobacterin is a spore suspension of probiotic strain B. subtilis 534 in 7% aqueous sodium chloride solution. In Russia, probiotic Sporobacterin has been used for last thirty years, in particular, for the prevention and treatment of postoperative bacterial and fungal infections in high-tech surgery, including transplantation [14-16]. To date, the results of long-term clinical and laboratory studies have been published, according to which the use of Sporobacterin in the technology of early postoperative management of patients with cardio-surgical and transplant profiles opens up possibilities for optimizing the clinical condition of patients, and also significantly reduces the duration of antibiotic therapy courses [17-20]. The purpose of this study was to determine the ability of the strain 534 to produce antimicrobial substances under in vitro cultivation conditions for the subsequent consideration of this strain as a medical antibiotics producer. Collection test strains and clinical isolates with different antibiotic resistance were used as test organisms.
Bacillus subtilis 534 is the basis of the probiotic Sporobacterin. The strain was deposited in the Microbiological Collection of the Gause Institute of New Antibiotics under the number INA 01122 (Russia). The sequence of the strain 534 is deposited in the GenBank database under the number KU051696 [21].
Submerged cultivation of B. subtilis 534 strain was carried out using modified medium #2 Gause of the following composition (%): glucose - 1, peptone - 0.5, tryptone - 0.3, NaCl - 0.5, tap water; pH 7.2-7.4. Spores of the strain 534 in an amount of 106/ml were injected into 750 ml Erlenmeyer flasks with 150 ml of the medium, after which the flasks were placed on the rotary shaker with rotation speed 220 rpm and incubated at 28 ℃. Antimicrobial activity of the culture liquid (CL) was determined at 2, 4 and 7 days of cultivation. Twelve cultivations were carried out with at least three parallel trials.
For surface cultivation of all test microorganisms universal for bacteria and fungi agar variant of the modified medium #2 Gause was used with the addition of 2% agar. Fungal strains Aspergillus niger INA 00760, Saccharomyces cerevisiae RIA 259 and bacterial strains Comamonas terrigena VKPM B-7571 and Leuconostoc mesenteroides VKPM B-4177 were grown at 28 ℃, all other strains, including clinical isolates and the probiotic strain B. subtilis 534, at 37 ℃. The duration of all test strains cultivation was 20 h.
Through the column filled with 80 ml of Amberlite XAD-2 sorbent, 0.8 l of culture liquid of Bacillus subtilis 534 strain was passed. Аntimicrobial components were desorbed with "n-butanol-acetone-water" (1:1:1) at neutral pH. The resulting eluates were evaporated in vacuum to dryness at 37 ℃ and the dry residue was dissolved in 60% aqueous ethanol. Further purification of the antimicrobial components was performed in the column filled with Kieselgel 60 silica gel (Merck) using stepwise elution with chloroform-methanol solvents (9:1, 8:2, 7:3, 6:4 and 5:5). The fractions from the column were tested for biological activity against test strains of Staphylococcus aureus INA 00761 (MRSA) and Sac. cerevisiae RIA 259. The active fractions was evaporated to dryness, dissolved in 1 ml of methanol each (800-fold concentration) and analyzed by thin layer chromatography (TLC) on silica gel plates in a solvent system ethyl acetate-methanol (1:4) followed by bioautography. Of the three selected active components antimicrobial properties the component #1 with Rf = 0.7 was studied in more details.
As tests for determining antimicrobial activity, we used international collection strains of Gram-positive and Gram-negative bacteria, fungi (Table 1), as well as clinical isolates of pathogenic microorganisms with different antibiotic resistance (Table 2, Table 3, Table 4 and Table 5). The species identification of clinical isolates of pathogenic microorganisms, as well as their susceptibility/resistance to antibiotics was carried out on an automated bacteriological analyzer for the identification of microorganisms Siemens MicroScan Walk Away - 96 Plus System. The antimicrobial activity of the culture liquid (CL) of B. subtilis 534 and its active component extracted was determined by agar-diffusion method. By 100 µl of CL were introduced into the wells with a diameter of 9 mm in the agar medium contaminated with the test organism. The selected antimicrobial component was applied to the disks with a diameter of 6 mm and placed on the surface of the agar medium.
Table 1: Antimicrobial spectrum against collection strains and the highest established level of antimicrobial activity in Bacillus subtilis 534 cultural liquid (CL). View Table 1
Table 2: Antimicrobial activity of the Bacillus subtilis 534 cultural liquid (CL) against clinical isolates of Staphylococcus spp. View Table 2
Table 3: The activity of the component #1 of the B. subtilis 534 antibacterial complex against clinical isolates of A. baumannii. View Table 3
Table 4: Antimicrobial activity of the component #1 of the B. subtilis 534 antibacterial complex against clinical isolates of K. pneumoniae. View Table 4
Table 5: Growth inhibition zones of the clinical isolates of pathogenic fungi under the action of the culture liquid (CL) of the strain B. subtilis 534 (diameters in mm). View Table 5
It was shown that the strain 534 produces and isolates to CL antimicrobial components with different antimicrobial spectrum, the maximum activity of which are achieved in different time (Figure 1). From Figure 1 it follows that in the CL there are at least four different compounds or groups of compounds that differ in antimicrobial activity:
 Figure 1: Dynamics of the strain B. subtilis 534 antimicrobial activity during submerged cultivation.
View Figure 1
Figure 1: Dynamics of the strain B. subtilis 534 antimicrobial activity during submerged cultivation.
View Figure 1
- Antibacterial activity only in respect of B. subtilis ATCC 6633 strain and only on the second day of cultivation; such activity may be due to bacteriocin;
- Antifungal activity, the peak of which falls on the second day and gradually decreases by the seventh day;
- Antibacterial activity against M. luteus NCTC 8340 and S. aureus FDA 209P (methicillin-sensitive S. aureus -MSSA), which is manifested on the third day of cultivation and increases on the seventh day;
- Antibacterial activity against B. pumilus NCTC 8241 and S. aureus INA 00761 (MRSA).
The maximum possible levels of antimicrobial activity in the above-described culture conditions are given in Table 1. From Figure 1 and Table 1 it follows that strain 534 inhibits the growth of Gram-positive bacteria and fungi. It is important to note that CL is active against resistant to methicillin and oxacillin Staphylococcus aureus (MRSA) and the Leuconostoc mesenteroides VKPM B-4177 test strain with a high level of natural resistance to vancomycin.
At the next stage, the antimicrobial activity of the culture liquid of strain 534 against 15 clinical isolates of the genus Staphylococcus was tested (Table 2). For two clinical isolates of S. capitis sbsp. urealyticus 1133 and S. epidermidis 2624 it was showed pronounced antimicrobial activity. It is important to note that strain 2624 is resistant to 15 medical antibiotics out of 20, so as effective drugs may be used only 5 antibiotics: daptomycin, linezolid, rifampin, synercid and vancomycin. Subsequently, in a chemical study of the culture liquid of strain 534, microbiological control with the release of the active components was carried out using the MRSA test strain INA 00761 (Figure 2).
Figure 2: Antibiotic sensitivity of two S. aureus strains: FDA 209P (MSSA, left) and INA 00761 (MRSA, right). On the left side of the cups there are disks with 1 mcg of oxacillin (OX, above) and 5 mcg of vancomycin (VA, below). On the right sides is a disc with 5 mcl of the component #1 from CL of the strain 534.
View Figure 2
Figure 2: Antibiotic sensitivity of two S. aureus strains: FDA 209P (MSSA, left) and INA 00761 (MRSA, right). On the left side of the cups there are disks with 1 mcg of oxacillin (OX, above) and 5 mcg of vancomycin (VA, below). On the right sides is a disc with 5 mcl of the component #1 from CL of the strain 534.
View Figure 2
The culture liquid of B. subtilis 534 showed no activity against collection strains of Gram-negative bacteria (Table 1). However, when isolating and, accordingly, increasing the concentration of component #1, which according to preliminary estimates consisted of polypeptide compounds, such activity was observed against a number of clinical isolates of Gram-negative bacteria (Table 3 and Table 4). Although the level of activity of component #1 in relation to A. baumannii and K. pneumoniae clinical isolates is low, further biotechnological and chemical research is reasonable, since multidrug-resistant bacteria are susceptible to component #1.For example, A. baumannii clinical isolates 1630, 2050, 2455, 2617, 3122, 3166, 3208, and 4354 as well as K. pneumonia 1878 are sensitive to component #1, but resistant to all tested modern medical antibiotics. Analysis of component #1 showed that it consists of no less than twenty substances, of which five are quantitatively predominant. Three of the five components confirmed antibiotic activity. According to preliminary data, it can be assumed that the active substances are of peptide nature.
The drug Sporobacterin is a suspension of B. subtilis 534 spores in 7% aqueous solution of sodium chloride that is intended for oral administration. We have previously shown that Sporobacterin itself does not possess antibiotic properties in vitro [21]. On the contrary, in the conditions of submersed cultivation of the strain 534 in a nutrient medium, a broad spectrum of antimicrobial activity is manifested. On the other hand, it is known that the stay of B. subtilis in the intestines of warm-blooded animals lasts from 10 to 30 days, and the bacteria are present both in the form of vegetative cells and spores. The process of germination and sporulation of spores is repeated several times before excretion from the body with feces [22,23].
Based on this data, we assumed that in the intestine and in the nutrient medium in flasks developmental processes of B. subtilis are similar and bacterial biosynthesis of antimicrobial substances in the digestive tract is possible. The ability of strain 534 to secrete antibacterial and antifungal substances may be the main explanation for the effectiveness of Sporobacterin in preventing the development and in treatment of bacterial and fungal infections along with such properties as enhancing immunity, stimulating the growth of normal intestinal microflora and secretion of digestive enzymes. It is especially valuable that the probiotic strain 534 is capable to produce substances that overcome the antibiotic resistance of clinical isolates of a number of Gram-positive bacteria and fungi. As for Gram-negative bacteria, it is also possible the manifestation of antimicrobial activity in vitro, albeit to with low intensity. Since B. subtilis 534 is capable to produce substances active against clinical isolates with a different spectrum of resistance to modern antibiotics, it can be assumed that these substances have different molecular targets in cells (or on the surface of cells) of pathogenic microorganisms. We are currently considering the B. subtilis 534 strain as a producer of antibiotics and are working on identifying the produced antimicrobial compounds.
Is it possible to detect new antibiotics in B. subtilis? Among the bacilli, the B. subtilis species takes the first place in the number of described antibiotics of various chemical nature, among which are polyketide antibiotics [24], phospholipids [25], polyenes [25-28], macrolactins [29] and various peptides that differ by chemical nature, by the mechanism of biosynthesis and by antimicrobial spectra. Some B. subtilis antibiotics are used as modern medicines. The peptide antibiotic bacitracin, one of the first antibiotics described in 1945 and formed by the B. subtilis strain isolated from a human wound, is still used in medicine [8]. A number of close antibiotics forming the bacitracin complex are currently known [30]. Due to the low toxicity in 2010, bacitracin was approved in the United States for the treatment of staphylococcal infections in newborns [9]. The combination of bacitracin with neomycin is effective against most clinical isolates of resistant staphylococcus (MRSA) that is very important for modern antimicrobial therapy [31]. Among the B. subtilis peptides, relatively large peptide antibiotics are bacteriocins, having a molecular weight of tens of thousands of Daltons, characterized by a narrow spectrum of antibiotic activity and acting on other strains of B. subtilis, i.e. acting as an intraspecific regulatory factor [8,32,33]. Among bacteriocins, antibiotics with a relatively small molecular weight of 5-10 kilo Dalton, which are called microcins, are isolated into an independent group [30]. Among the peptide antibiotics of B. subtilis, there is also a group of lantibiotics compounds, which include the rare thioether amino acid lanthionine and its derivatives, due to which internal thioester bonds are formed in the antibiotic molecule. Lantibiotics of B. subtilis, for example, subtilin and ericin, unlike bacteriocins, have a broad antimicrobial spectrum of action. Subtilin, consisting of 32 amino acids and having a pentacyclic structure, is similar in structure to the preservative nisin, widely used in the food industry and formed by Lactococcus lactis [9]. From fermented soybeans, traditional Korean food, B. subtilis strain the antibiotic SC-8 was isolated, which exhibits a narrow spectrum of antimicrobial activity against bacteria of the Bacillus cereus group and contributes to food preservation [31]. In B. subtilis also was described a large group of broad-spectrum lipopeptide antibiotics. These are oligopeptides synthesized on multienzyme complexes, to which fatty acids are then added. The amino acid chain and fatty acid bacillar lipopeptides are divided into three families. Representatives of the iturin family are heptapeptides with a lipophilic β-amino acid. They have a pronounced efficacy against mycelial and yeast phytopathogenic fungi [34,35]. Decapeptides with lipophilic β-hydroxy acid belong to the fenicine family and are characterized by the presence of ornithine. They are characterized by efficiency against filamentous fungi [36,37]. The third family includes surfactins - heptapeptides with β-hydroxy fatty acid, which are less effective against fungi, but exhibiting the most pronounced hydrophobic properties among these lipopeptides, which allow the formation of stable biofilms on the surface of plants and prevent their colonization by other microorganisms. In this case, B. subtilis antibiotics play an important role in ecosystems, contributing to the formation of biofilms and the colonization of area [32,38,39]. The oligopeptides of the lowest molecular weight, containing only two or three amino acids, include rhizocticins, which were isolated as antifungal phosphono-oligopeptides from the CL of collection strain B. subtilis ATCC 6633. These peptides contain a non-protein amino acid (Z)-2-amino-5-phosphono-3-pentenoic acid [34].
Since B. subtilis is a cosmopolitan species and is found on a wide variety of substrates, it is characterized by wide adaptability to various environmental conditions, which, in particular, is reflected in the wide variety of antibiotics produced, and we should expect further description of new antibiotics B. subtilis.
Strain B. subtilis 534 refers to probiotics and has long been successfully used in medicine, being the basis of the drug Sporobacterin. The use of Sporobacterin is not toxic and not burdensome to patients, but can be effective. Since it was established that strain 534 exhibits antimicrobial activity under conditions of submerged cultivation, we consider it as a potential producer of antimicrobial substances that overcome the multidrug resistance of pathogenic microorganisms. It is advisable to continue further chemical research and clinical trials of antimicrobial substances with the prospect of their use as medical antibiotics.
The authors thank all the reviewers for improving the quality of the manuscript. Also we want to thank Svetlana Dolgorukova for technical assistance.
All authors declare no conflicts of interest.
The research was carried out within the framework of the state assignment at the Gause Institute of New Antibiotics. The study was supported in part by the Russian Foundation for Basic Research, a grant of 17-00-00393\18.